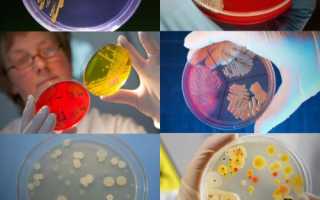

Выращивание бактерий – занятие увлекательное и полезное. Некоторым экспериментаторам такие опыты дают возможность убедиться в наличии жизни буквально на каждом миллиметре нестерилизованной поверхности, другие, более практичные естествоиспытатели преследуют исключительно утилитарные цели (использование бактерий в приготовлении продуктов питания, в изготовлении удобрений и даже в строительстве имеет определенную популярность). Чтобы понимать, как наладить процесс культивирования микроорганизмов в специально созданных условиях, следует иметь представление о фазах роста бактерий и о тех факторах, которые влияют на жизнь бактериальной популяции, растущей на питательных средах, контролируемых человеком.
Заселение: что нужно учесть
Перед заселением (инокуляцией) бактерий на поверхности с содержанием питательных веществ заводчик должен иметь достаточно информации о том, чем смогут дышать будущие бактериальные клетки и чем они могут питаться.
Врачи отмечают, что понимание фаз жизни и роста бактерий имеет ключевое значение для медицины и микробиологии. Бактерии проходят несколько этапов, включая лаг-фазу, экспоненциальный рост, стационарную фазу и фазу смерти. На начальном этапе, лаг-фаза, микроорганизмы адаптируются к новым условиям, что может занять от нескольких минут до нескольких часов. Затем начинается экспоненциальный рост, когда бактерии делятся с максимальной скоростью, что может привести к быстрому увеличению численности. В стационарной фазе рост замедляется из-за исчерпания питательных веществ и накопления токсичных продуктов. Наконец, в фазе смерти количество клеток начинает уменьшаться. Знание этих фаз помогает врачам разрабатывать эффективные методы лечения инфекций и контролировать распространение бактерий.

Дыхание
Практически все бактерии, которых можно вырастить в домашних условиях, являются либо аэробами (дышат исключительно кислородом), либо факультативными анаэробами (в зависимости от условий обитания могут менять химизм дыхательных процессов). Культуры облигатных (строгих) бактерий-анаэробов, которые гибнут в присутствии кислорода, можно выращивать только в бескислородной среде.
Питание
Состав любой среды, в которой необходимо добиться размножения бактериальной популяции, должен включать в себя вещества, содержащие углерод и азот. Существенные требования к необходимому питанию выдвигает автотрофность или гетеротрофность будущей популяции. Питающиеся неорганикой автотрофы требуют достаточного присутствия углекислого газа и карбоната (гидрокарбоната) кальция. Гетеротрофы, разлагающие органику, добывают себе еду из органических кислот, спиртов, углеводов и ароматических соединений. Потребность в азоте бактериальной популяции гетеротрофов удовлетворяется за счет органических соединений с аминогруппами – азотсодержащими органическими веществами.
Сама инокуляция бактерий на питательных средах производится либо капельным путем (вместе с жидкой субстанцией), либо механическим перемещением живой культуры с поверхности обитания на поверхность с подготовленным питанием. Можно провести ватной палочкой по поверхности стола и стряхнуть сухие частицы пыли на питательный раствор.
Фазы жизни и роста бактерий вызывают интерес у ученых и любителей микробиологии. В процессе роста бактерии проходят несколько ключевых этапов: лаг-фаза, экспоненциальная фаза, стационарная фаза и фаза гибели. На начальном этапе, лаг-фаза, микроорганизмы адаптируются к новым условиям, что может занять от нескольких минут до часов. Затем начинается экспоненциальный рост, когда бактерии делятся с максимальной скоростью, что приводит к резкому увеличению их численности.
Однако, по мере исчерпания питательных веществ и накопления токсичных продуктов, рост замедляется, и бактерии переходят в стационарную фазу, где количество делений уравновешивается с количеством погибающих клеток. В конечном итоге, в фазе гибели, численность бактерий начинает снижаться. Эти циклы роста не только важны для понимания экосистем, но и имеют практическое значение в медицине и промышленности, где контроль за ростом бактерий может предотвратить инфекции и улучшить процессы ферментации.

Рост, размножение и смерть
Фазы роста бактериальной популяции имеют выверенную микробиологами закономерность. На графике роста можно выделить четыре основных фазы, которые наглядно демонстрируют основные этапы развития бактерий на питательных средах.
Первый этап
Первая фаза роста популяции носит название лаг-фазы. Она начинается с момента заселения культуры бактерий на питательный раствор и заканчивается моментом адаптации переселенной популяции к новым условиям. В течение лаг-фазы клетки приспосабливаются к новым условиям жизни. В этой фазе отмечается задержка роста культуры и отсутствие размножения (деления) бактерий.
Продолжительность лаг-фазы зависит от возраста культуры (чем она старше, тем дольше идет приспособление) и от того, насколько различны в среде изначальной и в среде, где популяция культивируется, источники питательных веществ для бактериальной клетки. Чем больше эта разница, тем процесс адаптации дольше.

Второй этап
Следующая фаза роста живой культуры – развитие по экспоненте или экспоненциальная фаза. Приспособившись к условиям дыхания и питания в новой среде, клетки начинают активно делиться. В этой фазе у них самая высокая химическая активность, и они отличаются самой высокой жизнеспособностью. Во время фазы экспонентного роста клетки синтезируют наибольшее количество РНК – белка, который отвечает за создание новой ДНК по той информации, которая зашифрована в материнской ДНК.
Третий этап
С достижением максимального количества жизнеспособных клеток, которые способен “прокормить” имеющийся питательный раствор, фиксируется следующий этап роста живой культуры – стагнация, или стационарная фаза. Отсутствие достаточного питания замедляет все химизмы, которые происходят внутри клетки, скорость размножения падает, РНК практически не синтезируется.
В эту фазу роста популяции микробиологи наблюдают такое явление в бактериальном сообществе, как апоптоз. Апоптоз – альтруистическое поведение части бактерий, которые прекращают поддерживать в себе жизненно важные реакции (фактически, совершают суицид) тем самым отправляясь на корм выжившей части бактериальной популяции. Апоптоз дает возможность для размножения популяции в фазу стагнации.
Последний этап
Завершение жизненного цикла бактериальной клетки зависит скорее от внутренних факторов. Находясь в условиях ограниченного питания, клетки после фаз активного периода роста, размножения и стагнации накапливают в месте своего обитания продукты собственной жизнедеятельности: органические кислоты, автолиз, антибиотики, выработанные в результате бактериального метаболизма клетки.
Домашние условия
В домашних условиях колонии бактерий проще всего вырастить либо на жидкой среде (для этого подойдет бульон), либо на растительном желатине – агаре. Из двух возможных способов культивирования популяций (стационарный и непрерывный) дома можно наладить только стационарный (например, в чашках Петри).
Непрерывный предполагает постоянную подачу питательного раствора и откачку живой культуры. Этот процесс можно поддерживать только при наличии специального лабораторного оборудования, с помощью которого отслеживается необходимое количество требуемого субстрата и уровень заборов живой культуры из имеющегося бактериального инкубатора.
Вопрос-ответ
Как происходит рост бактерий?
У бактерий размножение происходит путём прямого бинарного деления. Содержимое клетки разделяется перетяжкой пополам, и образуются две дочерние клетки. Они растут и опять делятся. Бактерии размножаются быстро.
Что происходит в фазе роста?
Фаза роста – фаза развития компании, на которой доходы компании стремительно растут, в то время как она производит новые товары и увеличивает свою долю на рынке.
Советы
СОВЕТ №1
Изучайте различные фазы роста бактерий, такие как лаг-фаза, экспоненциальная фаза, стационарная фаза и фаза гибели. Понимание этих этапов поможет вам лучше контролировать условия для их роста и размножения, что особенно важно в микробиологии и биотехнологии.
СОВЕТ №2
Обратите внимание на факторы, влияющие на рост бактерий, такие как температура, pH, доступность питательных веществ и кислорода. Оптимизация этих условий может значительно ускорить или замедлить развитие колоний, что полезно в лабораторных и производственных условиях.
СОВЕТ №3
Используйте методы мониторинга, такие как подсчет колоний или измерение оптической плотности, для отслеживания изменений в численности бактерий на разных фазах их роста. Это поможет вам лучше понять динамику популяции и предсказать поведение бактерий в различных условиях.
СОВЕТ №4
Не забывайте о важности стерильности и чистоты в работе с бактериями. Контаминация может исказить результаты экспериментов и привести к неверным выводам. Используйте стерильные инструменты и среды, чтобы обеспечить надежность ваших исследований.